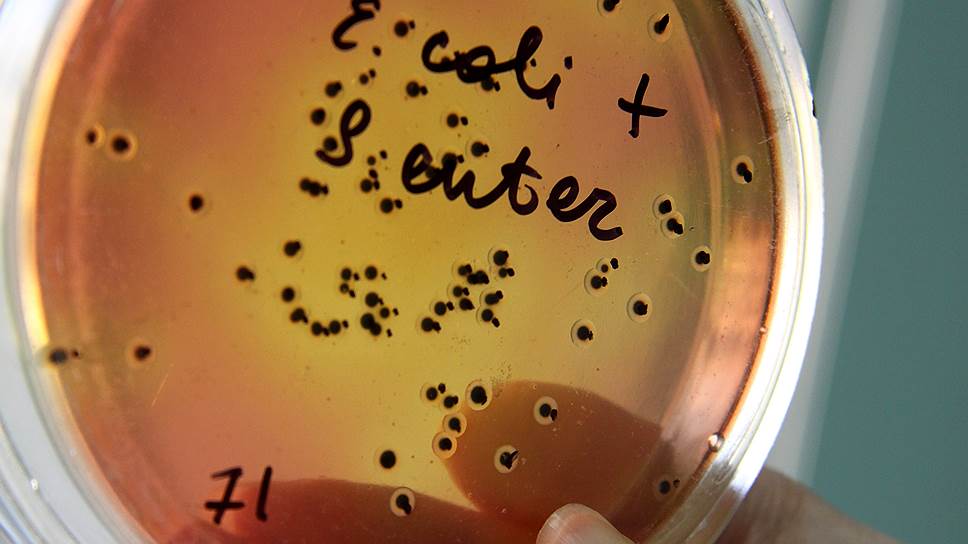

Вчера Россельхознадзор сообщил об обращении в Генпрокуратуру по подозрению в подлоге результатов исследований ОГБУ «Липецкая областная ветеринарная лаборатория». Речь идет об исследовании мяса птицы ОАО «Куриное царство» (структура «Черкизово»): продукция прошла проверку липецких ветеринаров и пошла на экспорт, но египетские ветслужбы нашли в ней сальмонеллу. Директор лаборатории Михаил Зибров, впрочем, вчера рассказал „Ъ“, что сальмонелла пока остается «виртуальной» — подтверждающих документов египетская сторона еще не представила.
К выявлению сальмонеллы в мясе «Черкизово» подключится Генпрокуратура
Фото: Максим Кимерлинг, Коммерсантъ
Об обращении в Генпрокуратуру Россельхознадзор вчера сообщил на своем официальном сайте. Из сообщения следует, что в сентябре липецкое ОАО «Куриное царство» поставляло в Египет партию мяса птицы. Перед отправкой продукция прошла проверку в ОГБУ «Липецкая областная ветеринарная лаборатория», где бактерий в нем не выявили. Но при получении товара египетские ветслужбы нашли в части партии (в 18 из 21 пробы) сальмонеллу. После этого с 25 по 28 сентября специалисты Россельхознадзора провели расследование в Липецкой области, по результатам которого были установлены «многочисленные грубые нарушения в работе указанной лаборатории, которые свидетельствуют о проведенных лабораторных испытаниях продукции ОАО “Куриное царство” в нарушение существующих нормативных документов». «В связи с нарушениями Россельхознадзор обратился в Генпрокуратуру РФ по подозрению в подлоге результатов исследований ОГБУ “Липецкая областная ветеринарная лаборатория” пищевой продукции по показателям безопасности, несущей угрозу жизни и здоровью людей», — пояснили в Россельхознадзоре. Также ведомство «до особого указания» приостановило сертификацию на экспорт подконтрольных товаров с территории Липецкой области, оформленных на основании исследований в этой лаборатории.
Детальнее о ситуации „Ъ“ вчера рассказал директор лаборатории Михаил Зибров. По его словам, сальмонелла в мясе пока остается «виртуальной», подтвержденной «только со слов египтян»: «Египетская сторона пока не представила никаких документов, никаких официальных протоколов, подтверждающих наличие бактерии». Господин Зибров пояснил, что в 2016-2017 годах «Куриное царство» поставило на экспорт в Египет восемь партий мяса общим объемом более 2 тыс. т: «До 2017 года все было нормально. Но в части последней партии — а было понятно, что она последняя и “Куриное царство” больше мясо в Египет поставлять не будет — неожиданно обнаруживается сальмонелла. То есть 2 тыс. т они съели нормально, а в части последней уже нашли проблемы. Может быть, дело вовсе не в сальмонелле? Говорить о ее наличии в мясе пока преждевременно».
«Компания в курсе происходящих событий, мы рассматриваем данный инцидент как ситуацию, которая требует незамедлительного решения, — сказали вчера “Ъ” в “Черкизово”. — У нас на производстве прошла внутренняя проверка, и сейчас мы тесно сотрудничаем с Россельхознадзором, чтобы вместе как можно быстрее разобраться в ситуации». Более подробно инцидент в компании вчера предпочли не комментировать.
Группа «Черкизово» получила право на экспорт мяса птицы в Египет в апреле 2016 года. Речь шла о трех предприятиях — Васильевской птицефабрике в Пензенской области, «Лиско-Бройлере» в Воронежской области и «Курином царстве» в Липецкой. Разрешение выдавала Генеральная организация ветеринарной службы Министерства сельского хозяйства и мелиорации Египта по результатам инспекции предприятий в феврале-марте 2016 года. Египетские ветеринары «тщательно обследовали санитарное состояние и стандарты работы птицефабрик», подчеркивали тогда в «Черкизово»: «Кроме того, все три фабрики были проверены на соблюдение исламских правил убоя животных — “халяль”. Инспекция египетских ветеринаров подтвердила соответствие птицефабрик этим стандартам». Поставки продукции в Египет начались в течение двух месяцев после получения разрешения. По предварительным оценкам «Черкизово», на египетское направление пришлось до 15% экспортных продаж компании в 2016 году.


